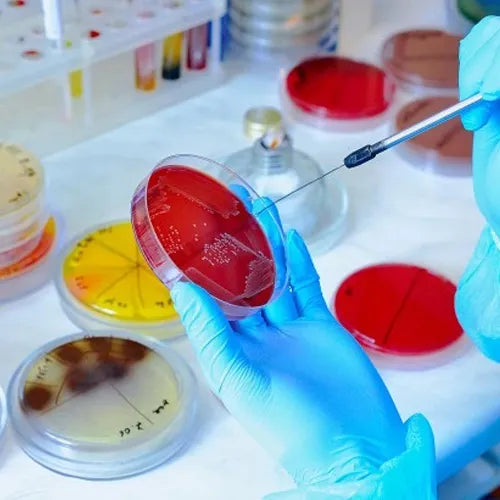
MCD LAB

Colección
AHLSTROM


AHLSTROM
ALL AMERICAN


ALL AMERICAN
AMBIDERM


AMBIDERM
ANÁLISIS DE AGUA


ANÁLISIS DE AGUA
BRANNAN


BRANNAN
CONSUMIBLES PARA LABORATORIO


CONSUMIBLES PARA LABORATORIO
CRISTALERÍA


CRISTALERÍA
EQUIPOS


EQUIPOS
FELISA


FELISA
FERMONT


FERMONT
FILTRACIÓN


FILTRACIÓN
GERBER INSTRUMENTS


GERBER INSTRUMENTS
HACH


HACH
HANNA


HANNA
Inicio


Inicio
KIMAX


KIMAX
KONTES


KONTES
MCD LAB

MCD LAB
MEGALAB


MEGALAB
MICROBIOLOGÍA


MICROBIOLOGÍA
